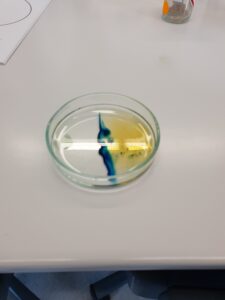

Wasser ist gleich Wasser? Dieser Frage ist der Leistungskurs Chemie (12. Jg.) von Herrn Sander nachgegangen und untersuchte im Schülerlabor Quantensprung am Hereon-Forschungszentrum in Geesthacht Mineralwässer und Proben aus der Elbe mit qualitativen und quantitativen Methoden. Dabei haben sie den Calcium- und Eisengehalt auf verschiedene Arten bestimmt und neue, oft bunte, Nachweisreaktionen kennengelernt.